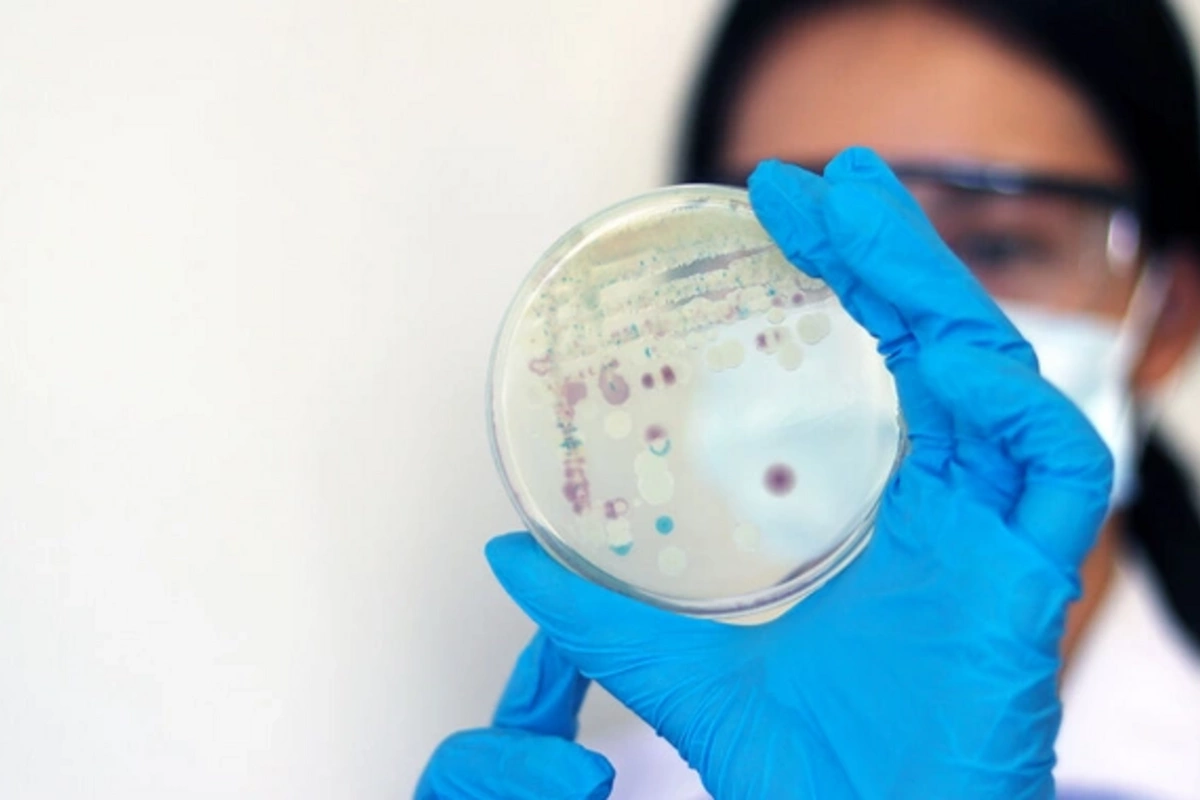
Учёные узнали, какой грибок способен выжить на Марсе

20 апр , 20:55
0
Грибок из стерильных лабораторий NASA оказался способен пережить полёт на Марс и условия Красной планеты. К такому выводу пришли учёные из Лаборатории реактивного движения (Jet Propulsion Laboratory), опубликовавшие результаты исследования в журнале Applied and Environmental Microbiology (AEM).
Всё началось с находки в самых чистых помещениях на Земле — стерильных залах NASA, где собираются космические аппараты. Даже в этих зонах с жесточайшим санитарным контролем обнаружились споры грибка Aspergillus calidoustus, не желающего сдаваться без боя.
Чтобы проверить его на прочность, учёные воссоздали в лаборатории полный набор марсианских «кошмаров»: леденящий холод, мощное ультрафиолетовое и ионизирующее излучение, а также крайне низкое давление. Условия, при которых большинство живых организмов обречены на гибель, споры Aspergillus calidoustus выдержали с поразительной стойкостью.
Эксперименты продемонстрировали, что грибок способен сохраняться на каждом этапе потенциальной марсианской миссии — от сборочного цеха до поверхности Красной планеты. Уничтожить его удалось лишь одним способом: одновременным воздействием экстремального холода и высокой дозы радиации.
Руководитель исследования Кастури Венкатешварэн уточнил, что полученные данные не означают неизбежного заражения Марса. Однако они ясно сигнализируют: контроль биологической безопасности при подготовке межпланетных миссий нуждается в серьёзном ужесточении. Устойчивые микроорганизмы, случайно попавшие на другую планету, могут поставить под удар весь поиск внеземной жизни, исказив его результаты.
Не менее серьёзную тревогу вызывают и перспективы пилотируемых полётов: живучие микробы способны колонизировать системы жизнеобеспечения и нарушить их работу. Исследователи убеждены — детальное изучение подобных организмов позволит выработать более надёжные стратегии планетарной защиты и снизить риски на пути человечества к освоению космоса.